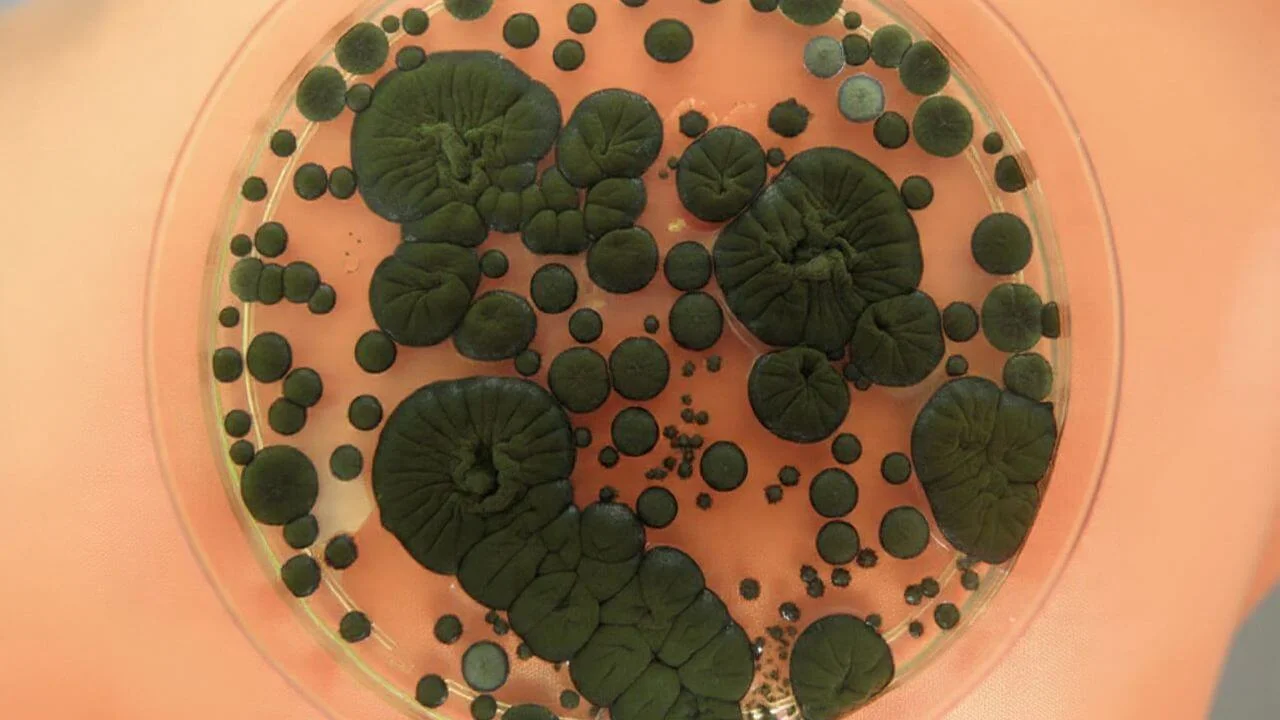
The melanized fungus Cladosporium sphaerospermum in this petri dish was sent to the ISS to test its potential as a living radiation shield for space missions.

Space Scientists Grow a Black Fungus on the ISS and Watch It Thrive Under Radiation
A radiation resistant black fungus grew faster on the International Space Station than on Earth, and sensors beneath its biomass recorded fewer ionizing events compared to a control surface.
When discussions about life in space arise, most people imagine astronauts, advanced spacecraft, and robotic explorers. Very few imagine ordinary black mold adapting to life in orbit. Yet this is precisely what a team of researchers observed after sending a dish containing a melanized fungus to the International Space Station. The fungus, Cladosporium sphaerospermum, is known on Earth for its ability to tolerate and survive environments that would challenge many organisms, including radioactive sites. The experiment sought to understand whether such a fungus could grow in a low Earth orbit environment and whether its dense melanin layer could influence the radiation field around it.
The International Space Station is constantly exposed to cosmic radiation, which creates substantial stress for biological systems. Discovering an organism that not only survives but grows effectively in this environment provides a new perspective on how biological solutions might support long term space exploration. This experiment was therefore not just about growing mold. It was about exploring how living systems respond to radiation rich environments and how such systems might one day support astronauts on distant missions.
The Problem
Radiation is one of the greatest obstacles for sustained human presence beyond Earth. High energy particles can damage DNA, harm tissues, and increase long term health risks. Traditional radiation shields rely on heavy materials, which increase launch mass and limit mission flexibility. Scientists have therefore explored alternative strategies that are lighter, self sustaining, and suitable for long duration missions.
Melanized fungi present a potential option because melanin strongly absorbs radiation. The pigment also has unique chemical properties that allow it to dissipate energy safely. Studies from places such as Chernobyl have shown that certain darkly pigmented fungi tend to move toward radiation sources and may even experience improved metabolic activity in such environments. This led researchers to test whether similar behavior would occur in space, where radiation exposure is continuous and far more intense than on Earth.
The question guiding the work was straightforward. If melanized fungi are naturally resilient to radiation, would they grow more effectively in orbit, and if so, could their biomass slightly reduce the radiation detected beneath it?
The Approach
To answer these questions, scientists designed a compact and autonomous fungal experiment. They used a split Petri dish, placing the melanized fungus on one side and a no growth agar control on the other side. Two independent radiation sensors were positioned beneath the dish, one under the fungus and one under the control. This allowed the team to track ionizing events separately for each half.
The payload also included cameras that captured images every thirty minutes, along with temperature and humidity sensors. The entire system was controlled by Raspberry Pi computers housed within a CubeLab facility aboard the ISS. This setup allowed the experiment to run automatically for nearly a month without requiring astronaut handling.
On Earth, the researchers ran three matched ground controls. These followed the same time temperature profile recorded on the ISS to ensure a valid comparison. By analyzing optical density from images, the team estimated fungal biomass growth and applied mathematical growth models to compare specific growth rates.
The Breakthrough Discovery
Faster Growth in Space
One of the most striking observations was how quickly the fungus spread across its growth medium in orbit. It reached full plate coverage in roughly two days, which is rapid for this species. When the researchers computed the exponential growth rate, the space grown fungus displayed an average specific growth rate about one point two times higher than that of the Earth controls.
Interestingly, the temperature aboard the ISS rose to slightly above thirty one degrees Celsius during the experiment. Under normal circumstances, such temperatures are not ideal for this species on Earth. This makes it unlikely that heat alone explains the growth advantage. The temporal alignment between radiation exposure and the increased growth suggests that radiation might have played a stimulatory role.
Reduced Ionizing Events Beneath the Fungus
Throughout the experiment, the radiation sensor beneath the fungal side registered fewer ionizing counts than the sensor beneath the control side. The cumulative difference was modest, yet the separation became clearer as the fungal biomass matured. During early growth, when melanin content was minimal, the two radiation curves were nearly identical. Later, when a dense, dark biomass had formed, the control side consistently recorded more radiation events.
This pattern implies that the melanin rich biomass provided a small degree of radiation attenuation. Although the sensors do not measure absorbed dose in standard units, they do detect relative differences in ionizing particle events. The fact that the difference appeared only after the fungus produced substantial biomass strengthens the interpretation that biological shielding, however slight, was occurring.
Why It Matters
A Living Shield That Repairs Itself
If future experiments confirm these results, melanized fungi could play a role in radiation protection strategies for long term space missions. Unlike metal or water shields that must be transported in full mass from Earth, living shields can be grown from a tiny starter culture and maintained in situ. Their ability to regenerate makes them valuable for missions where maintenance and self repair are essential.
Melanin is already recognized as a powerful absorber of harmful radiation. The idea that melanin rich organisms could form part of a protective layer around habitats or equipment introduces a biologically driven approach to shielding. Combined with regolith or other locally available materials, fungal composites could one day help astronauts build protective structures on the Moon or Mars.
Possibility of Radiation Enhanced Metabolism
The work also highlights a broader biological question. Some melanized fungi appear to convert ionizing energy into enhanced metabolic activity. Although this remains an open area of research, the observation that the ISS culture gained a growth advantage supports the idea that such organisms may be capable of using radiation in beneficial ways.
This concept opens a path toward living materials that not only withstand radiation but might also adapt and function better in its presence. This could be significant for biotechnology in space, including biomanufacturing systems that thrive in environments that challenge traditional organisms.
Caveats and Future Directions
The experiment offers an important proof of principle, but several limitations should be considered.
Only a single orbital run was conducted, and it involved one fungal strain. Microgravity effects, temperature fluctuations, or other ISS specific factors may have influenced growth. Radiation sensors were not dosimeters, so energy dependent shielding effects remain uncertain. Additionally, the fungal biomass was thin, meaning any shielding effect would naturally be small.
Future experiments should include:
- Multiple fungal isolates tested simultaneously.
- Energy resolved radiation detectors to quantify shielding performance.
- Larger biomass volumes to test scalability.
- Exposure to controlled particle types such as protons and heavy ions.
- Integration experiments with lunar or Martian regolith.
Such work would clarify whether biological shielding can meaningfully reduce radiation risk in deep space where conditions are harsher than in low Earth orbit.
Conclusion
The ISS experiment involving Cladosporium sphaerospermum demonstrates how an organism adapted to extreme environments on Earth can continue to surprise scientists when taken into space. The fungus grew more quickly in orbit than on Earth and coincided with a measurable reduction in radiation events beneath its biomass. Although the shielding effect was modest, the findings are clear enough to justify larger and more sophisticated investigations.
Biology has a remarkable capacity for adaptation. Understanding how melanized organisms interact with radiation could reshape future approaches to space habitation, habitat construction, and biotechnology. As humanity prepares for long term missions beyond Earth, these early findings offer a glimpse of how living systems might become partners in overcoming the challenges of space.
The research was published in Frontiers in Microbiology on July 05, 2022.
This article has been fact checked for accuracy, with information verified against reputable sources. Learn more about us and our editorial process.
Last reviewed on .
Article history
- Latest version
- Last updated by Dayyal Dungrela, MLT, BSc, BS
Reference(s)
- Averesch, Nils J. H.., et al. “Cultivation of the Dematiaceous Fungus Cladosporium sphaerospermum Aboard the International Space Station and Effects of Ionizing Radiation.” Frontiers in Microbiology, 05 July 2022, doi: 10.3389/fmicb.2022.877625. <https://www.frontiersin.org/journals/microbiology/articles/10.3389/fmicb.2022.877625>.
Cite this page:
- Posted by Tamseel Fatima